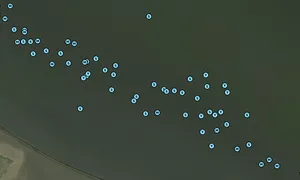

HOZA, MMSI: 205757610
 Belgium
Belgium
Follow the journey
Images of HOZA
Journey statistics
Preferred harbour type
2026
100% marina
natural harbour 0%
2025
80% marina
natural harbour 20%
2024
86% marina
natural harbour 14%
2023
67% marina
natural harbour 33%